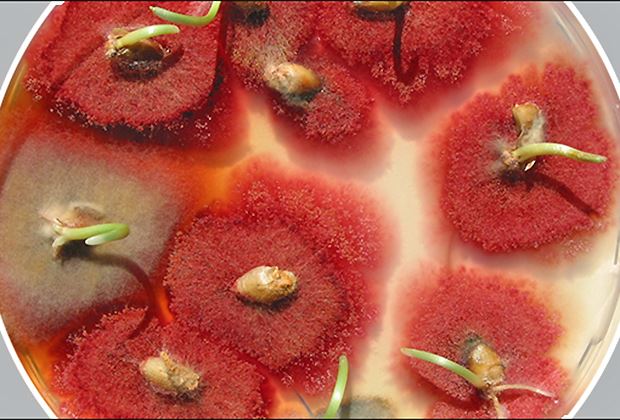

In der Schweiz werden auf rund 60 Prozent der offenen Ackerfläche Fusarium-empfindliche Nutzpflanzen wie Weizen, Weizen-Roggen und Mais angebaut. Forscher von Agroscope haben entdeckt, dass der Einsatz des in der Natur vorkommenden Pilzes Clonostachys rosea den schädlichen Pilz zurückdrängen kann.
Fusarien gehören zu den weltweit wichtigsten Schadpilzen von Mais und Getreide. Enge Mais- und Getreidefruchtfolgen fördern Fusarien-Infektionen, weil beide Nutzpflanzenarten Fusarien-anfällig sind. Solche Infektionen führen zur Bildung von Pilzgiften (Mykotoxine), die die Gesundheit von Mensch und Tier gefährden. Praxistaugliche und nachhaltige Strategien gegen Fusarien sind daher gesucht.
Die häufigste Fusarienart Fusarium graminearum überwintert auf Pflanzenresten aus dem Vorjahr und bildet dort Fruchtkörper, aus denen sogenannte Askosporen ausgeschleudert werden. Das grösste Risiko für den Fusarienbefall von Weizen und Gerste ist feuchtes Wetter kurz vor und während der Ährenblüte sowie der Anbau von Mais als Vorfrucht.
Agroscope-Forschende haben festgestellt, dass der in der Schweiz vorkommende Pilz Clonostachys rosea Fusarien auf Mais-Ernterückständen effizient in die Schranken weist. So konnte dieser nützliche Pilz im Feld die Produktion des Fusarien-Mykotoxins Deoxynivalenol bis zu 90 Prozent reduzieren.
Um eine Fusarien-Infektion hervorzurufen, legten die Agroscope-Fachleute infizierte Maisstängel ins Feld (halb-natürliche Infektionsbedingung). In einer neuen Versuchsreihe wird erstmals der Einsatz von Clonostachys rosea direkt beim Mulchen überprüft. Beim Mulchen werden Ernterückstände zerkleinert und auf dem Feld belassen.
Das Ziel ist es, eine anwendbare und nachhaltige Lösung in einem einzigen Arbeitsschritt zu entwickeln. Dabei werden die Agroscope-Forscher untersuchen, wie sich die Clonostachys-Etablierung, der Fusarium-Befall, der landwirtschaftliche Ertrag und die Mykotoxinbelastung in Weizen entwickeln.